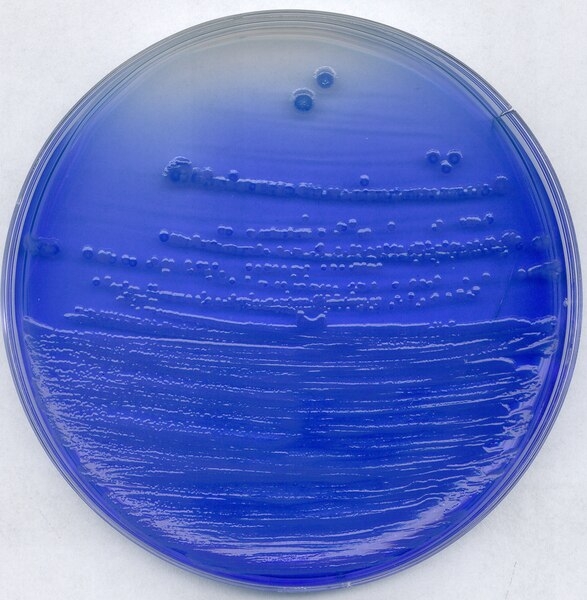

| Tên sản phẩm: | China-blue lactose agar for microbiology |
| Code: | 1023480500 |
| Hãng - Xuất xứ: | Merck - Đức |
| Ứng dụng: |
- Dùng để phân tích vi sinh trong phòng thí nghiệm trường học, viện nghiên cứu,... - Để nuôi cấy, phân biệt và liệt kê các loại vi khuẩn trong sữa. |
| Tính chất: |
- Hình thể: chất rắn, màu xanh nhạt - Giá trị pH (25 °C): 6,8 - 7,2 |
| Bảo quản: | Bảo quản +15°C đến +25°C. |
| Quy cách đóng gói: | Chai nhựa 500g |